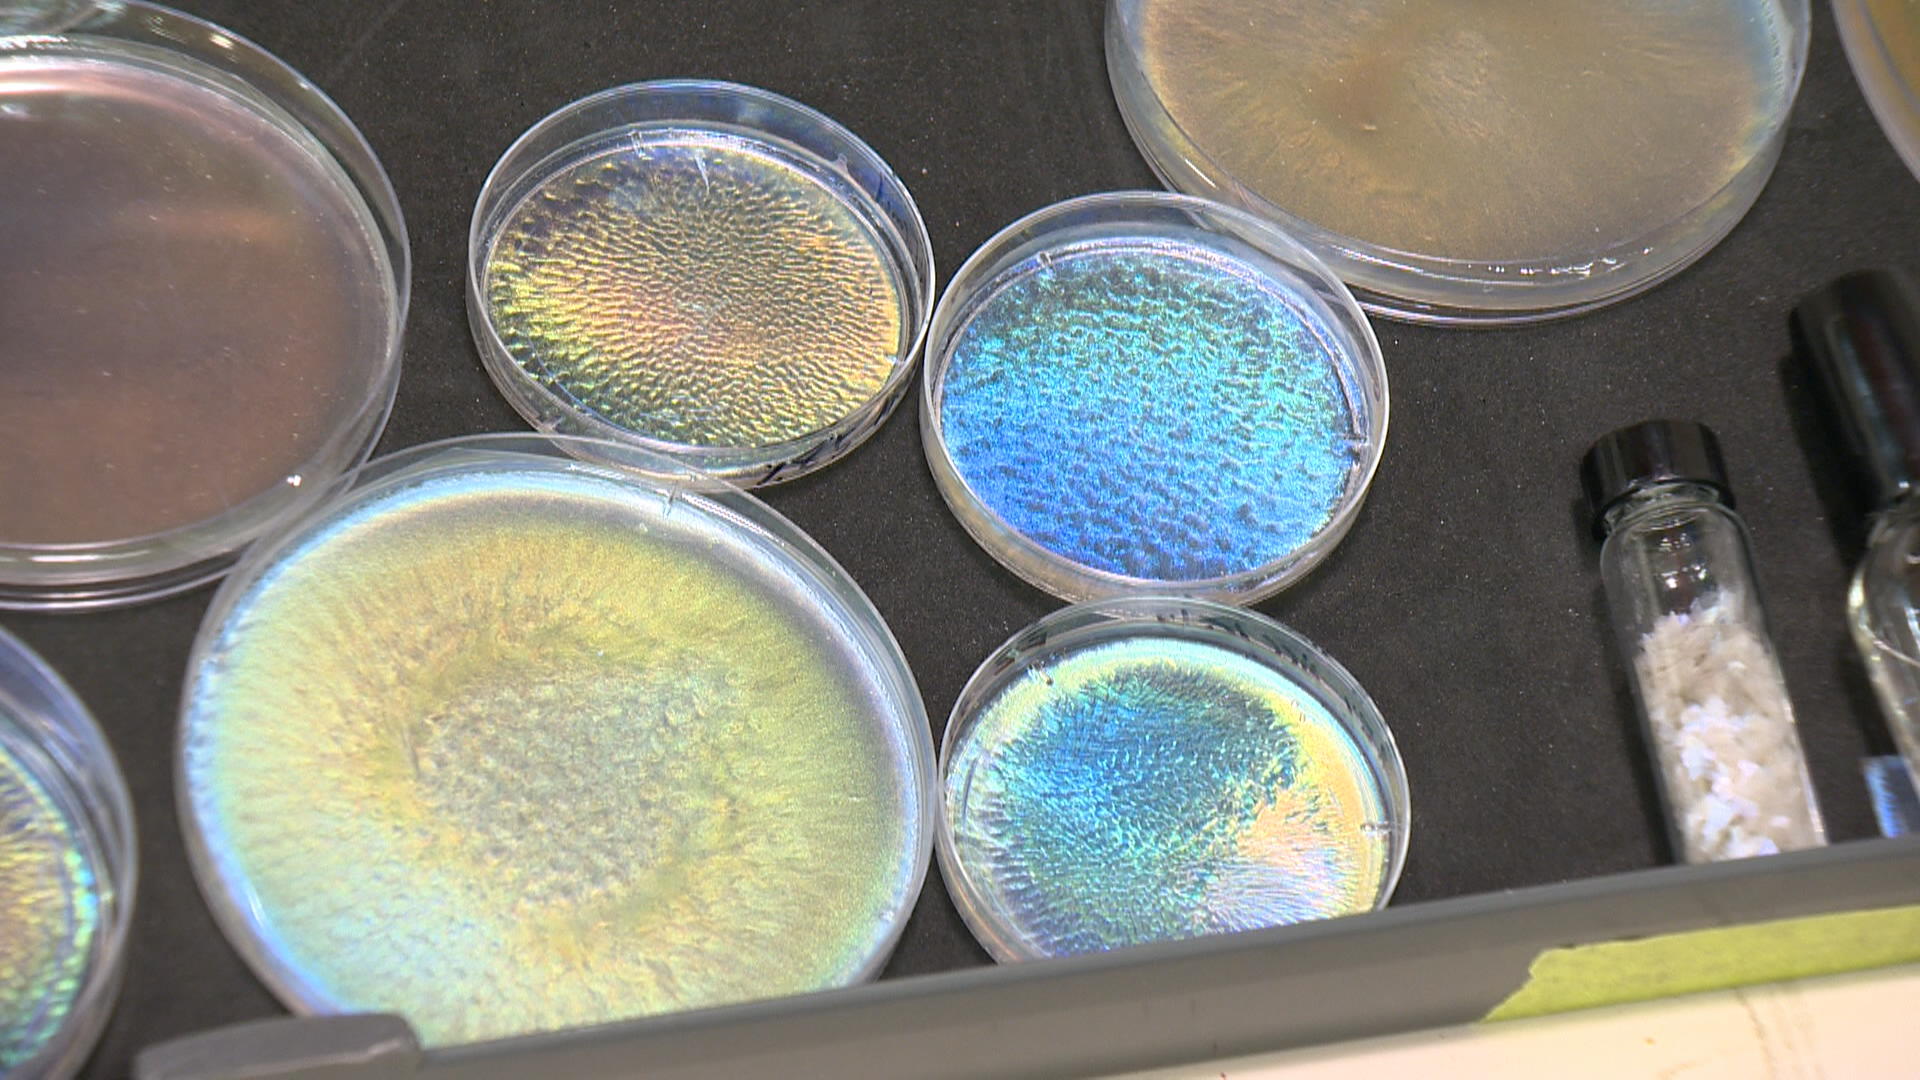

Glitter is a big part of the holiday season. It’s used in gift wrapping, kids’ costumes and makeup, and it’s oftentimes hard to clean up.

But researchers at the University of Saskatchewan have created an alternative, noting that run-of-the-mill glitter is made of microplastics but their creation is biodegradable.
“In modern glitter production, aluminum and polyethylene terephthalate (microplastics) are usually combined to produce the final product,” Amin Babaeighazvini said.
Babaeighazvini is a PhD student at USask part of the research team that created ChiralGlitter, a plant-based product that can replace glitter.
“Although I have developed a number of biodegradable films over the past eight years, we have recently developed biodegradable and edible glitters from natural resources that do not include microplastics.”
The research team says microplastics have significant impacts on ecosystems, noting that they are non-biodegradable, environmentally toxic and can reach remote parts of the world if they enter waterways.
“We use a biomaterial such as wood or agricultural waste to synthesize cellulose nanocrystals,” Babaeighazvini said.

Get breaking National news
“Then, we fabricate functional materials from those nanocrystals, such as these biodegradable and edible glitters. The thing that makes this eco-friendly and non-toxic is the cellulose. Nanocrystals are from nature.”
Babaeighazvini’s research supervisor, Bishnu Acharya, who is also an associate professor of engineering, says they’re aiming to see this product used in the cosmetic industry, adding that there are many uses for cellulose nanomaterials.
“In our lab, we always focus on how to get high-value material from something which is underutilized,” Acharya said.
“And one of the applications is a bio-glitter. But the goal is always, how can we maximize the value of the underutilized biomass and create a value chain to drive the bio-economy?”
Acharya said that based on how they change the structure of the biodegradable glitter, they can change the colour that gets reflected from the light.
He added they are working to create a business plan to produce and sell this product.

Comments
Want to discuss? Please read our Commenting Policy first.